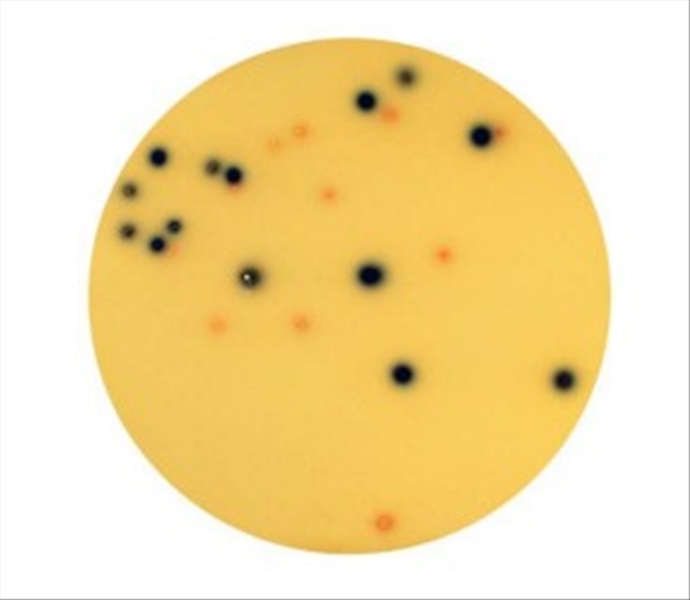

CHROMOGENIC COLIF - ECOLI 20 PZ
- Disponibilità limitata
- Codice: L030659
Utente NON autorizzato per procedere con il preventivo.
Area Riservata Aggiungi ai preferitiDescrizione
TERRENI IN PIASTRE DA 90 mmTerreno cromogenico per l'identificazione simultanea dei coliformi e di Escherichia coli (APAT CNR-IRSA N°7030)
Y8541299













